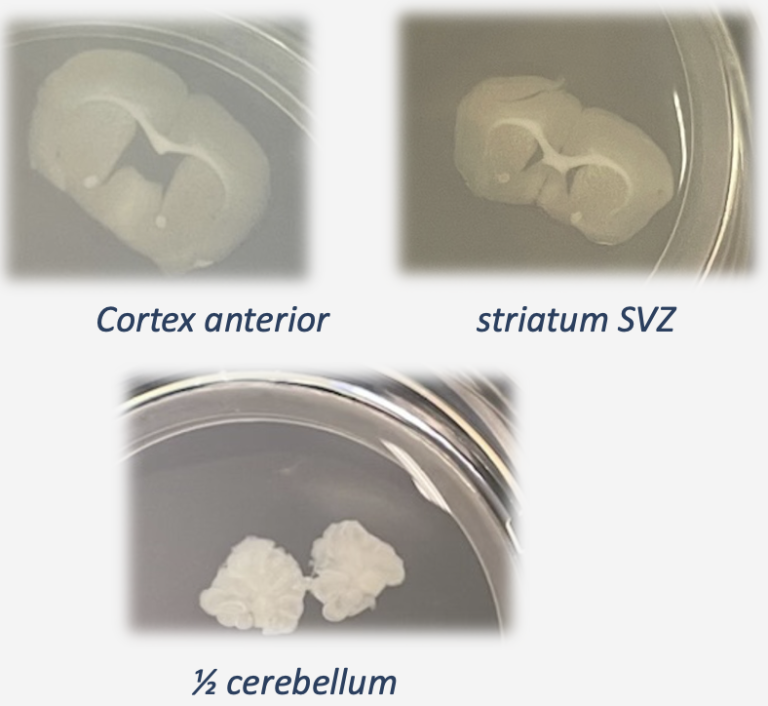

«Understand Physiology of CNS*
&
cure neurological diseases »
Through Research, Development and Treatment.
* Central Nervous System
L'ADN de Research PIECES
Parce que plus de 90 % des futures molécules thérapeutiques échouent en essais cliniques
par manque de modèles performants robustes & transférables.
Research PIECES à l'honneur dans le Forbes France
Research PIECES et notre Présidente, à l’honneur dans Le Forbes France dans un article intitulé : « Research PIECES : accélérer la recherche en neurosciences grâce à des modèles biologiques nouvelle génération »
3D-Living System de
tissu nerveux
Propose des modèles précliniques innovants et sur mesure pour disséquer les mécanismes moléculaires, cellulaires et tissulaires afin de mieux comprendre la physiologie et d'accélérer la découverte de traitements contre les maladies neurologiques (neurodégéneratives, glioblastome, etc.)

3D-Living Systems
Modèles flexibles & sur-mesure générés par nos experts pour répondre aux diverses problématiques
Design de protocole
Protocole personnalisé designé par nos experts & adapté aux
problématiques

Prestations de service
Services sur-mesure adaptés aux questions & réalisés par nos experts pour les étapes de recherche préclinique
Nos partenaires
Depuis le début de l'aventure Research PIECES, nos partenaires ont joué un rôle clé dans le développement de nos projets et continuent de nous suivre à ce jour !
Leurs contributions permettent d'atteindre nos objectifs communs. Nous les en remercions !








Téléphone: +33 549453725
Courriel: contact@researchpieces.com
Adresse: 1 rue Georges Bonnet, POITIERS, 86000, France



